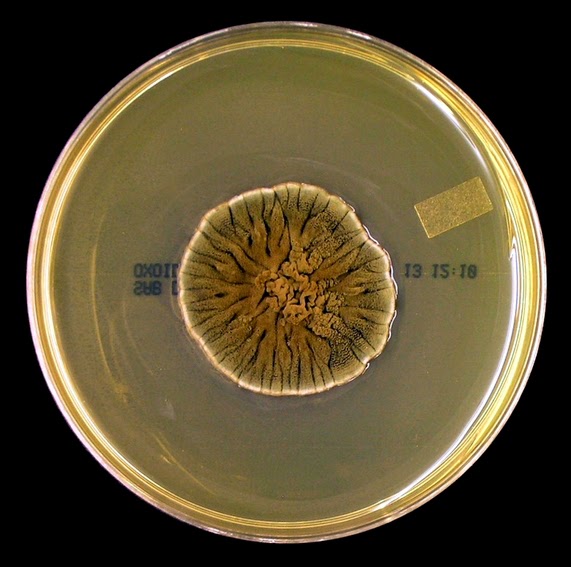
Fun With Microbiology (What's Buggin' You?) Cladosporium species

Cladosporium es un género de hongos que incluye algunos de los mohos interiores y exteriores más comunes. Las especies producen colonias verde oliva a o negras y tienen conidios pigmentados oscuros que se forman en cadenas simples o ramificadas. Muchas especies de Cladosporium se encuentran comúnmente en material vegetal vivo y muerto. Algunas especies son patógenos de plantas, otras parasitan otros hongos. Las esporas de Cladosporium están dispersas por el viento y son a menudo extremadamente abundantes en el aire exterior. En interiores Las especies de Cladosporium pueden crecer en las superficies cuando hay humedad. Cladosporium fulvum, causa del moho de la hoja del tomate, ha sido un elo genético importante, en que la genética de la resistencia del anfitrión se entiende.[2] En la década de 1960, se estimó que el género Cladosporium contenía alrededor de 500 especies patógenas y saprotrópicas, pero esta cifra se ha incrementado a más de 772 especies.[3] El género Cladosporium está estrechamente relacionado con hongos filamentosos negros del orden Dothideales.[4] Las especies de Cladosporium suelen ser altamente osmotolerantes, creciendo fácilmente en medios que contienen glucosa al 10% o NaCl al 12-17%. Raramente se cultivan en medios que contienen 24% de NaCl o 50% de glucosa y nunca se aíslan de medio con NaCl al 32% o mayor. La mayoría de las especies tienen cadenas de esporas muy frágiles, lo que hace extremadamente difícil preparar una montura para la observación microscópica en la que las cadenas de conidios se conservan intactas.[5]
Especie
Referencias
Enlaces externos
- Cladosporium en Index Fungorum (en inglés).